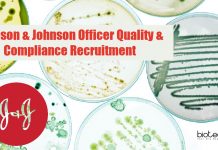
Johnson & Johnson Officer Quality & Compliance Recruitment J&J Microbiology Jobs

IIT Kanpur Project Post-Doc Fellow Jobs For Biophysics, Immunology
IIT Kanpur Jobs 2022 - Project Post-Doc Fellow Vacancies
IIT Kanpur Jobs 2022 - Project Post-Doc Fellow Vacancies. Biophysics, Immunology and Virology Jobs. PhD Post-doc...
CCMB PhD Program Admission August 2022 – Online Application Process
CCMB PhD Admission 2022 August - Apply Online
CSIR-CCMB PhD Admissions 2022. CCMB PhD Admission 2022 August - Apply Online. Application Portal Open for CCMB...
THSTI Biotech, Bioinformatics, Life & Biological Sciences Research Jobs – Up To Rs. 67,000...
THSTI Research Jobs 2022 - Biotech, Bioinformatics, Life Sciences
THSTI Research Jobs 2022 - Biotech, Bioinformatics, Life Sciences. THSTI Project Jobs Available 2022. THSTI Research...
PhD Programme In Genetics & Plant Breeding at Calcutta University
PhD Admissions Calcutta University 2022 in Genetics & Plant Breeding
PhD Admissions Calcutta University 2022 in Genetics & Plant Breeding. PhD Admission 2022 at the...
NISER PhD Program Admission 2022-23 (Summer Session)
NISER PhD Admission 2022-2023 (Summer Session), Apply Online
NISER PhD Admission 2022-2023 (Summer Session), Apply Online. NISER Admission to Ph.D Program: 2022-23 (Summer Session). NISER...
CDFD Research Scholars Program 2022 (RSP – II – 2022), Apply Online
Research Scholars Program CDFD 2022 (RSP - II - 2022), Apply Online
Research Scholars Program CDFD 2022 (RSP - II - 2022), Apply Online. CDFD...
Biotecnika Times Newsletter 22.03.2022 FSSAI Internship 2022, NCCS Project Training
Biotecnika Times - FSSAI Internship 2022, NCCS Project Training, IISER
FSSAI Internship Scheme For April 2022 With Stipend, Apply Online
FSSAI Internship 2022 Scheme For April,...
Non-Medical SRF Job For Life Sciences at AIIMS Delhi, Applications Invited
AIIMS Delhi SRF 2022 - Non-Medical Life Sciences Job
AIIMS Delhi SRF 2022 - Non-Medical Life Sciences Job. Non-Medical SRF job opening at AIIMS. MSc...
FSSAI Internship Scheme For April 2022 With Stipend, Apply Online
FSSAI Internship 2022 Scheme For April, Apply Online
FSSAI Internship 2022 Scheme For April, Apply Online. Food Safety and Standards Authority of India Internship 2022....
10 Preparation Strategy & Tips For CSIR NET June 2022 & Dec 2022 Exam
CSIR NET June 2022 & Dec 2022 Exam Preparation strategy
With CSIR NET June 2022 Life Science Exam around the corner & CSIR NET Dec...
Project Research Associate Job For PhD Life Sciences at RCB, Apply Online
RCB Vacancy 2022 - Project Research Associate Job For Life Sciences
RCB Vacancy 2022 - Project Research Associate Job For Life Sciences. PhD life sciences...
NCCS Project Training 2022 Biological Sciences For 6 Months or 1 Year
NCCS Project Training Programme 2022 Biological Sciences
NCCS Project Training 2022 Biological Sciences - Applications Invited. NCCS Pune Project Training Programme 2022 for MSc, BTech,...
Breast Cancer Metastasis Project JRF Job For Life Sciences at ACTREC
ACTREC Job 2022 - JRF Vacancy For MSc Life Sciences
ACTREC Job 2022 - JRF Vacancy For MSc Life Sciences. MSc life sciences can apply...
MACS – Agharkar Research Institute JRF Vacancy For Biotech, Biochem, Life Sciences
MACS ARI Vacancy For JRF - Life Sciences, Biotech, Biochem & Zoology
MACS ARI Vacancy For JRF - Life Sciences, Biotech, Biochem & Zoology. MSc...
IISER Berhampur PhD Admission July 2022 For Biological Sciences
IISER Berhampur Admissions 2022 For PhD Biological Sciences
IISER Berhampur Admissions 2022 For PhD Biological Sciences. Biological Sciences PhD Admission July 2022 at IISER. IISER...